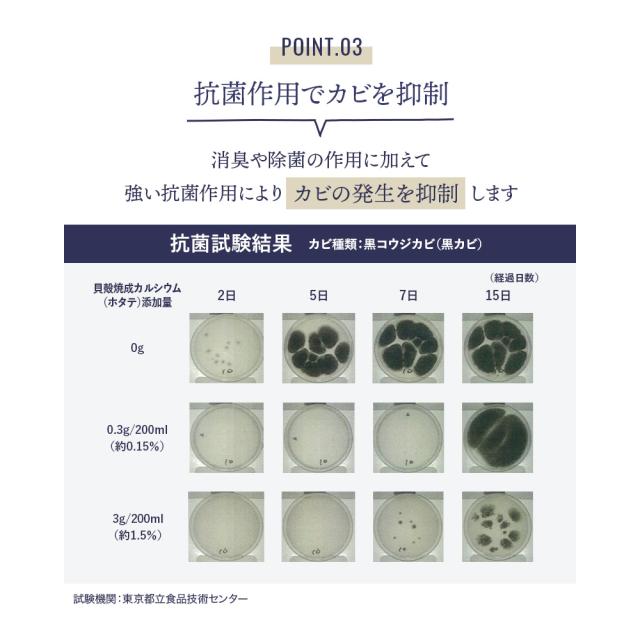

【商品レビューでポイント+5%】 消臭FACTORY パウダーボトル 靴の消臭剤 消臭FACTORY パウダー ボトルタイプ 消臭 粉 除菌 靴の消臭 70g 日本製 国産 天然成分 におい 臭い 臭い消し フットケア 角質 足のにおい 消臭剤 天然素材 靴用 靴下 除菌 RIORES
(1件)
Pontaパス特典
サンキュー配送
1,380円(税込)
0ポイント(1%)
商品説明

| 商品仕様 | |
| 商品の特徴 | ・貝殻由来の天然成分100% 無香料・無着色なのにしっかり除菌・消臭。口に入っても大丈夫。 (※除菌、消臭、カビ抑制、安全性については試験を行なっています。) ・革靴、スニーカー、パンプス、上履きなど、あらゆる靴に。ニオイを元から断ち、しっかり除菌します。 (※すべての菌を除菌するわけではございません。) ・人と環境にやさしい消臭・除菌剤です。 |
| 内容量 | 70g |
| 成分 | 水酸化カルシウム(ホタテ貝殻焼成パウダー) |
| 生産国 | 日本 |
| 使用上の注意 | ※アルミ製品には使用しないでください。 ※色落ちしやすいもの、シミの心配のあるものには使用しないでください。 ※目や喉の粘膜に付着した場合は多量の水で洗い流し、異常を感じた場合は直ちに医師にご相談ください。 ※塩素系除菌剤・漂白剤と同時に使用することはおやめください。 ※スプレーで使用する場合は吹き付け箇所が素材により白残りする場合があります。 ※アレルギー体質、皮膚の弱い方は使用前に医師にご相談ください。 ※使用後は蓋を閉め、湿気の少ないところで保管してください。 |
| 備考 | 写真の色はお使いのブラウザによって異なる場合がございます。あらかじめご了承ください。 ※メーカー都合により、予告なく仕様変更となる場合がございます。 |
消臭FACTORY パウダーボトル
レビュー
商品の評価:



 5.0点(1件)
5.0点(1件)
- しっかり消臭してくれます!
- 中学生の部活男子のシューズが臭うので消臭剤を探していたところ、スプレーでなく、またボトルから振り入れられるこちらの商品を見つけてこれだ!と購入しました。 最初の1回だけではまだ臭っていましたが、続けて使っているうちに殆ど気にならなくなりました。 ボトルを振るだけなので子どもが自分でやってくれるのも助かります。 詰め替え用もあるのでこれからもお世話になると思います。 いい商品に出会えてよかったです。
すべてのレビューを見る
お店の情報
\公式LINEスタート!新規登録で100円OFFクーポン配布中♪/
お店の評価:



 -点(0件)
-点(0件)
連絡・応対
-
配送スピード
-
梱包
-














